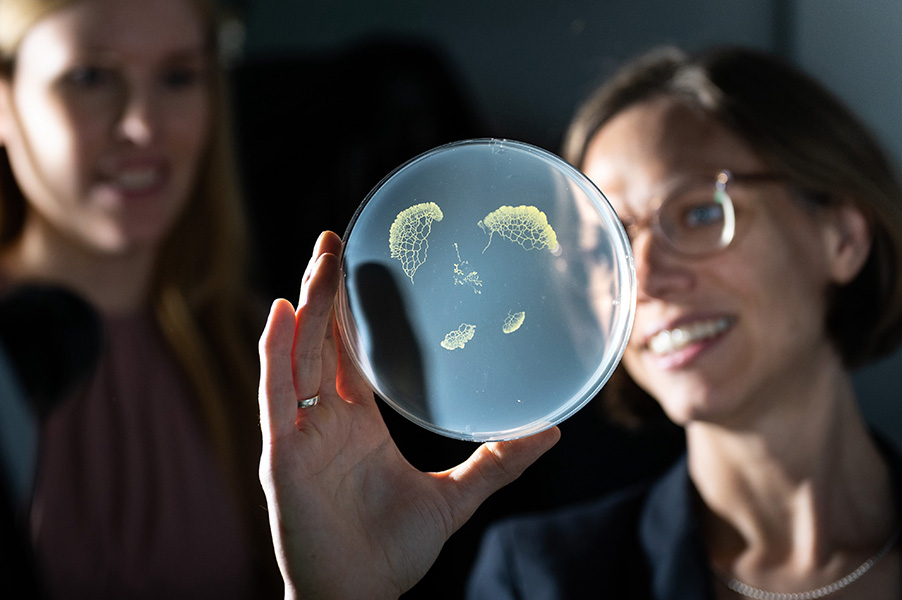
Photograph of Karen Alim holding up a petri dish on which a slime mold is growing.

Tales of a very clever slime mold
In its quest to feed, avoid nasty substances and just generally live its life, the brainless, one-celled Physarum polycephalum performs some impressive tricks of learning and memory
Support sound science and smart stories
Help us make scientific knowledge accessible to all
Donate today
Sixteen years ago, a brainless, unicellular organism blew our human minds. And it continues to fascinate and surprise researchers to this day.
Scientists had known that some slime molds of the species Physarum polycephalum consist of one giant, pulsating cell that keeps changing shape as it moves around and branches out to access food and avoid unpleasant things like salt or light. But it took a 2010 experiment led by Japanese biologist Toshiyuki Nakagaki of Hokkaido University to reveal the depths of its sophistication. When Nakagaki placed the oat flakes that Physarum likes in a pattern mimicking the cities surrounding Tokyo, the slime mold’s branches almost exactly reproduced the efficient transport connections between them that humans had taken years to develop.
From the center of a petri dish, the slime mold Physarum polycephalum extends branches to find food in this time-lapse video.
CREDIT: © DUSSUTOUR / CNRS
To Karen Alim, a theoretical physicist starting a postdoctoral project at Harvard University at the time, that study was a revelation. “I was like, ‘Wow, this is so crazy.’ A single cell that solves complex tasks appealed very much to me as a physicist.” Perhaps, Alim thought, she could apply her training to make sense of this clever creature with its network of contractile tubes and constantly pulsating currents.
So Alim and colleagues grew Physarum on a jelly-like substance called agar and carefully watched and recorded its behavior under the microscope. They measured the strength and direction of the fluid flow in its network of tubes. Then they simulated what they’d seen in mathematical models.
The result? Through studies like this, as Alim recounts in the Annual Review of Condensed Matter Physics, she has become convinced that the flow of fluid can be a way of transmitting information, and she’s working to understand the underlying mechanisms. Other researchers, meanwhile, are continuing to uncover new, intriguing behaviors in Physarum, a creature that appears able to learn, remember and make decisions — all without a brain.
Researcher Karen Alim (right) and her colleagues grow Physarum polycephalum in petri dishes containing a nutrient-rich agar medium.
CREDIT: STEFAN WOIDIG / TUM
The flow of memory
Though Physarum is a single cell, the large body it forms can often be easily seen by the naked eye, growing to more than a foot in diameter under favorable conditions. It looks like a central blob from which a network of vein-like tubes emanates — larger tubes, then smaller tubes that fan out from them. Inside those tubes, cytoplasmic fluid is rhythmically flowing back and forth, supplying all parts of the cell with what they need. In nature, the slime mold is found in damp, dark spots like forest floors and decaying logs.
Many of the studies revealing Physarum’s unexpected skills revolve around its most important concern: finding food. Whenever Physarum encounters something edible, the outer wall of tubes near the food become soft. As a result — due to the pressure of the constantly moving fluid inside its tubes — that part of the body spreads out like a fan. This fan then slowly morphs into a network of even tinier tubes. Under the microscope, this looks like a river delta network of yellow slime feeding into the larger tubes of Physarum’s body.
How does it happen? Alim, who now works at the Technical University of Munich in Germany, figured out that encounters with food lead to an increase in local fluid flow within the tubes. This exerts greater shear force on the tube walls. The walls in that region grow thinner, allowing the tubes to expand.
Inside the slime mold Physarum polycephalum’s branching, pulsating body, currents of fluid flow back and forth to transport food and other molecules. These currents are key to the organism’s ability to move, change its shape and learn.
CREDIT: DELESCLUSE & DUSSUTOUR / CNRS
The opposite happens when Physarum encounters something awful like salt or light that it wants to get away from. In response to a repellent, the tube walls stiffen and contract, which redirects fluid flow elsewhere.
In sum, researchers now understand that where the flow is stronger, the tubes expand, and where the flow is weaker, they shrink. This interplay of shrinking and expansion in different areas of the body is what reorganizes the shape of Physarum’s tube network, causing it to approach food and avoid things like salt.
More recently, Alim and colleagues discovered just what creates a tube network as efficient as Tokyo’s transport links. It ties into something crucial about the fluid flow in Physarum’s body: Tube walls respond to changes in flow with some delay. First the flow increases. Then, slightly later, the tube expands in response, causing the flow to decrease. This causes the tube to shrink, again with some delay.
The result, Alim found, is that the best-positioned tubes will grow larger and larger and receive more and more flow, while others will fade away — and hence, over time, a super-efficient network of links will form.
Put another way, Alim adds, you could say that the shape of the network (and its underlying fluid flow dynamics) helps Physarum to remember. Appropriately sizing its branches in accordance with food sources it has encountered recently makes for a simple but effective way to recall where food can be found.
Recent work in Alim’s lab suggests it’s not just the shape of the network that helps Physarum remember, but also how, when and where it contracts the walls of its branches. For example, she says, putting food in a certain location leads the slime mold to respond with a certain pattern of contractions and move toward the food. Between experiments, the contraction pattern diminishes, but if food is put in the same spot, it reappears, more quickly than before. In one experiment, a persistent wave of contractions caused a slime mold to keep crawling in one direction for hours to get away from a light source, long after the light had been switched off, which suggests it still remembered it.
Like all of us, Physarum polycephalum has its food preferences, as this time-lapse video shows.
CREDIT: © DUSSUTOUR / CNRS
Salt and slime
The finding is reminiscent of a study by Audrey Dussutour, a biologist working on the same species, now at the National Centre for Scientific Research in France. In 2019, Dussutour had reported something interesting: After a few attempts, Physarum took less time to cross a nasty salty patch inside its dish while moving toward a food source — implying some kind of learning. The effect remained even after the slime mold had spent time in the dormant state it adopts under stressful conditions.
Since the slime mold absorbed and retained some salt, it’s possible that this lowered the shock of encountering it again and allowed it to move faster, says Dussutour. So in a recent experiment, as yet unpublished, she used light as the repellent instead. Physarum still shaved down its travel time with repeated exposures, even though light isn’t retained the same way salt is. Dussutour suspects that contraction patterns may persist and store information “similar to the way waves of activity in our brain can store information,” she says.
In addition to the information stored in the layout and contractions of its tubes, says Dussutour, Physarum has another way to “remember”: the trail of slime it leaves wherever it goes. “Avoiding slime is a convenient way to make sure it’s exploring new places rather than retracing its own trail,” she says.
In the wild, Physarum polycephalum is often found on dead plant material, as shown in this time-lapse video.
CREDIT: © DUSSUTOUR / CNRS
Dussutour was also able to show that slime molds can learn about each other: They are sensitive to aspects of each other’s behavior. “They will approach others that have access to food, and avoid ones that are starving or stressed,” she says. “Remarkably, they also prefer to approach young individuals.”
Older slime molds become very slow and fragile, she adds. “We have some in the lab that are now 5½ years old…. We hardly dare to use them anymore. But intriguingly, when they go through dormancy, or fuse with a younger individual, it’s as if they’re young again.”
For a better understanding of the slime molds’ mysterious ways, it would be very helpful to find out what exactly they’re up to in the wild, says behavioral ecologist Tanya Latty of the University of Sydney. “Almost everything we know about their behavior is based on experiments done in a lab,” she says — experiments that focus on the large, multi-nucleus forms of the creatures, not the single-nucleus, microscopic amoeba state in which they spend most of their lives.
So Latty’s research group has been collecting wild slime molds to investigate. “They’re often found on rotting logs, but we’ve also found them in the leaf litter just in front of our building. People have also found them on house plants. They’re everywhere,” she says.
Latty suspects that the large form, with its various ways of learning, allows Physarum to consume a lot more food in preparation for making the spores it needs to spread. Physarum may be far less clever in its microscopic form, she adds, if its surprising behavior really depends on its ability to branch and contract its tubes. “But who knows? We didn’t think they were capable of anything when we started to study them.”
10.1146/knowable-021126-1
TAKE A DEEPER DIVE | Explore Related Scholarly Articles
